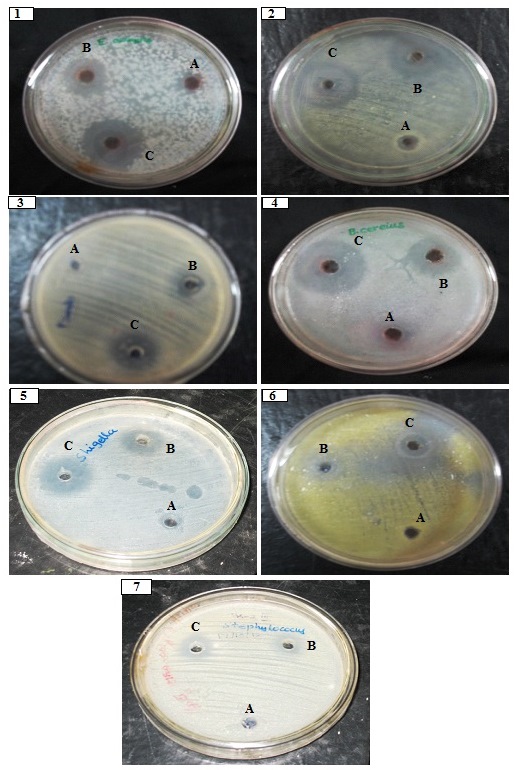

Int J Pharm Pharm Sci, Vol 6, Issue 7, 179-182Original Article
ANTIBACTERIAL ACTIVITY OF INDIGENOUS ENTOMOPATHOGENIC FUNGUS METARHIZIUM ANISOPLIAE AGAINST CLINICALLY ISOLATED HUMAN PATHOGENS
K.RAVINDRAN*, G.SATHISHKUMAR, C. RAJKUBERAN, S.SIVARAMAKRISHNAN
Insect molecular biology laboratory, Department of Biotechnology and Genetic Engineering, Bharathidasan University, Tiruchirappalli, Tamilnadu, India 620024
Email: ravindmbs@gmail.com
Received: 03 Jan 2014 Revised and Accepted: 10 Feb 2014
ABSTRACT
Objectives: The aim of this study was to determine the bactericidal effect of indigenously isolated entomopathogenic fungus Metarhizium anisopliae against clinically isolated human pathogens such as Bacillus subtills, Pseudomonas spp, Proteus spp, Staphylococcus aureus, E.coli, Shigella spp, Entrocooci spp.
Methods: The isolated fungus was mass cultivated in liquid state fermentation and the extracellular products were extracted with dichloromethane. With the support of preparative high performance liquid chromatography (HPLC) the extract was separated and the active metabolites were characterized. Further, the extract was tested for its bactericidal efficacy against clinically isolated human pathogens via well diffusion method. Briefly, different concentrations of the extracts were loaded onto the bacterial culture growing in nutrient agar plates.
Results: Formation of clear zones after 24h of incubation indicates the significant inhibitory action of active metabolites present in the three different concentrations (25µl, 50µl, 75µl) of crude extract. High level exhibit best inhibitory activity was found against B.subtills (26.4±0.1),
Conclusion: The findings of this preliminary study gives overview idea about the differential anti-bacterial property of M. anisopliae and additionally it will help us to find specific antibiotic products for biomedical applications.
Keyword: Entomopathogens, M. anisopliae, Human pathogens, Bioactive compound, HPLC.
INTRODUCTION
The entomopathogenic fungus life cycle is associated with the synthesis and secretion of different active metabolites, including extra-cellular enzymes and low-molecular weight compounds (toxins).These toxic byproducts mainly helps the organisms to withstand and protect themselves from invading pathogens [1-2]. In general fungi produce a wide range of secondary metabolites with diverse biological activities like antibiotics, cytotoxic substances, insecticides, compounds that promote or inhibit growth, attractor, repellent etc.,[3]. Chemical constitution and metabolic fluxes of fungus will vary accordingly to their specific ecological conditions [4]. These chemical constituents have enormous significance for the surviving humanity and being exploited with highest degree of commercialization in medicine and agriculture industries. In particular, Entomogenous fungi secrete an array of relatively low molecular weight secondary metabolites some of which have antibiotic properties while others are important pathogenicity determinants. Although these metabolites are often referred to as toxins, little is known about their properties, production, and spatial distribution. Most studies emphasis the dominant metabolites secreted in nutrient rich media, however there is increasing evidence of inter- and intra-specific variation in metabolite production, with some strains or species secreting more toxic metabolites than others [5]. The entomopathogenic filamentous fungi M. anisopliae is a widespread pathogen has been used as microbial agent to control many important several agricultural pest and medically important products of commercially synthesized to antagonistic compounds.[6-8].Hence in the present study we have screened the active metabolites of entomopathogenic fungi M.anisopliae for its antimicrobial effect against tested human pathogenic organisms.
MATERIALS AND METHODS
Microbial Cultures
The indigenous M.anisopliae isolates was obtained from insect molecular biology laboratory in Department of Biotechnology and Genetic engineering, Bharathidasan University. In this isolated on previous screened against model insect G.mellonella. [9].
Liquid state fermentation (SSF)
The aerial conidium was harvested from 15-days old sporulating cultures by scraping the surface with a spatula and suspended the conidia in sterile 0.05% aqueous (w/v) Triton X-100. The isolate was further cultivated in 250 ml Erlenmeyer flasks containing 100 ml of Czapek Dox agar medium with 0.5% (w/v) bactopeptone, pH 7.0. The flasks were inoculated with 1 ml of conidial suspension containing 107 conidia/ml and incubated at 25 ± 1 ºC on an orbital shaker at 150 rpm for 9-12 days. The mycelium and impurities were removed by centrifugation (8000 g, 30 min, 4 ºC). In addition, the culture filtrate was filtered through a Buchner funnel lined with Whatman filter paper No. 1 to ensure complete removal of conidia and hyphen debris.
Solvent extract
The crude culture filtrate was mixed with dichloromethane (DCM), solvent (3×500) for 2 hours followed by cheese cloth filtration to remove the biomass. Then the solvent was saturated with rotary vaccum evaporator for solvent free extracts. The extracted metabolites were further stored at -4 ºC for further study.
Quantitative HPLC Analysis
The crude extract was dissolved in methanol and purified using preparative HPLC. Acetonitrile-soluble residue was flash chromate graphed on a Merck (Darmstadt, Germany) K-60 silica gel column (230–400 mesh, 240325 mm) employing a 50-ml step-wise methylene dichloride– methanol (95:5, at the beginning) solvent gradient to give desired polarities. Further purification was performed on a Preparative HPLC column (Merck LiChrosorb, 7 mm, 250310 mm). A typical running gradient was as following: 0 min (0% acetonitrile) 30min (40%acetonitrile) 40 min (50% acetonitrile) 60 min (50% acetonitrile under the condition to collect the two fractions at 3.2min and 7.2min. Fractionated samples were collected and tested for biological activity.
Test microorganism
The test human pathogenic bacteria such as a B.subtills, Pseudomonas spp, Poteus spp, S.aureu, E.coli, Shigella spp, Entrocooci spp were obtained in the department of Biotechnology and genetic engineering. Cultures were maintained at −80 ◦C on glycerol stock. Clinically isolated strains were sub-cultured in nutrient broth for 24 h at 30 °C.
Antibacterial assay
Effects of fungal fermentation extracts of purified compounds were tested against human pathogenic bacterial strains such as bacteria such as E.coli, Enterococcus spp Shigella spp, Pseudomonas spp, S. aureus. B. subtills and Proteus spp. The antibacterial assay was performed by agar well diffusion method. Briefly, the wells were then filled with 25 µl, 50 µl, 75µl, of the fungal crude extract that was already dissolved in DMSO. Plates were monitored for the development of zones of inhibition48hrs. Inhibition zones developed due to active antibacterial metabolites were measured after 24 hours of incubation for bacteria. Streptomycin (25mg ml-1) and ampicillin (25mg ml-1) were used as positive control and DMSO act as a negative control.
RESULTS
In this study, the two yellow oil major compound fractions were collected on3.3 min and 7.2 min from preparative HPLC [Fig1]. The two major fractions were considered and tested against human pathogenic bacteria; it shows potential inhibitory action against tested pathogens. The bioactive compound activity was determined according to inhibition range after 48hrs; the zone inhibition was measured from 5.2±0.6 to 26.4±0.1 [Table1]. High level of zone of inhibition was noticed against B.subtills (26.4±0.1), and lowest activity against Pseudomonas spp (14.1±1.2). The antibacterial activity of active metabolites was compared with standard antibiotic discs Streptomycin (25µg/ml-) and ampicillin (25µg/ml-) and negative control DMSO.

Fig. 1: HPLC analyses of crude extract of M.anisopliae
Table 1: Antibacterial activity of crude extracts M anisopliae against Human pathogenic bacteria
| Organisms | Zone of inhibition (mm) | ||
| 25 µl | 50µl | 75 µl | |
| B.subtills(ATTCC6099) | 8.2±0.5 | 22.1±0. | 26.4±0.1 |
| Pseudomonas spp | - | 8.4±0.7 | 14.1±1.2 |
| Poteus spp | - | 11.6±0.2 | 22.4±0.6 |
| S.aureus(ATCC6538 ) | - | 13.6±1.1 | 15.1±1.2 |
| E.coli (ATCC1229) | 5. 2±0.6 | 24.6±1.1 | 25.2±11 |
| Shigella spp | - | 14.1±1.2 | 19.3±1.2 |
| Entrocooci spp | 4.5±0.7 | 16.2±11 | 24.2±0.6 |
| Streptomycin (+) | 11.3±1.1 | 28.3±1.0 | 29.6±1.1 |
| Ampicillin (+) | 13.0±0.5 | 26.1±1.1 | 28.3±03 |
| DMSO (-) | - | - | - |
DISCUSSION
Generally, fungi releasing a wide variety of secondary metabolites in order to kill their natural enemies like invading pathogens and insects to get nutrients. In particular, EPF are unique outstanding microbial entities owing to their resourceful ability to produce plethora of bioactive compounds and from the dependence of their morphological differentiation. For instance, M.anisopliae produces an insecticides cyclodepsipeptide called destruxin which inhibits the growth of various bacterial strains [10-13]. In most cases the secondary metabolites play a crucial role in improving the fungal adaptability to withstand diverse natural habitats [14]. On the other hand these metabolites act as a signaling molecule for niche establishment in fungal–plant or fungal–insect interactions, or act as stress protectors [15]. However, the exact function of many secondary metabolites for the producing fungi, including Metarhizium spp. is still unknown.Several chemical classes have identified in Metarhizium spp such as cytochalasins C and D[16], myroridins,destruxin A,B and E [17],viridoxin,swainsonine,helvonic acid [18],12-hydroxyovalicin[19], hydroxy- fungerin,7-desmethyl analogues of fusarinCand(8Z)-fusarinC, serinocyclins A and B and aurovertins [20]. M.anisopliae metabolites are toxic to wide range of microbes, insects [22].
Most of these metabolites were isolated from mycelia or from fermentation extracts. There is much less information regarding the secondary metabolites exclusively or differentially present in Metarhizium conidia. [23-24].
In our study, the most reliable protocol has been developed to obtain the fungal secondary metabolites. Dichloromethane was used to extract the bioactive principles and evaluated against human pathogenic bacteria; the results were statistically significant in relation to negative control, also observed minor efficiency of entophytic secondary metabolites extracted with methanol regarding antimicrobial tests [25]. The demonstrated on antimicrobial activity of fungal secondary metabolites produced by entophytes from Luehea divaricata against the human pathogenic bacteria E. coli and S. aureus [26]. Castlebury et al. studied the activity of mycotoxin on B. cereus, B. mycoides, B. pumilis, B. sphaericus, P. alvei, P. azotofixans, P. macerans, P. macquariensis, P. pabuli, P. pulvifacien and P. validus. The results clearly suggest the antimicrobial potential of mycotoxin [27].
Fig. 2: Antimicrobial activity of crude extract of M.anisoliae on (A) 25µl (B) 50µl,(C) 75µl, against human pathogenic bacteria (1) Entrococci spp,,(2) E.coli, (3) Pseudomonas spp (4) B.subtilis,(5) Shigella spp,(6) Proteus spp, (7) S.aureus
CONCLUSION
To summarize in this study we have successfully screened the antibacterial potential of indigenously isolated entomopathogenic fungus M.anisopilae. The results showed that the fungal extract was much more potent when compared with standard antibiotics; it showed dose dependent inhibitory action against all the tested pathogens. Further investigations will be focused on identifying and structural elucidation of specific antibacterial compounds.
CONFLICT OF INTERESTS
Declared None
REFERENCES
- Strasser H, Vey A, Butt T. Are there any risks in using entomopathogenic fungi for pest control, with particular reference to bioactive metabolites of Metarhizium, Tolypocladium and Beauveria species Biocontrol Science and Technology. Agric Biol Chem 2000;10:717-35.
- Vey A, Hoagland R, Butt TM, Butt CW, Cabi. Toxic metabolites of fungal biocontrol agents. 311-46 p.
- Bandani AR, Khambay BPS, Faull J, Newton R, Deadman M, Butt TM. Production of efrapeptins by Tolypocladium species (Deuteromycotina:hyphomycetes) and evaluation of their insecticidal and antimicrobial properties. Mycological Research 2000;104:537-44.
- Keller,C, Maillard M, Keller J, Hostettmann, K. Screening of European fungi for antibacterial, antifungal, larvicidal, molluscicidal, antioxidant and free-radical scavenging activities and subsequent isolation of bioactive compounds. Pharmaceutical boil., 2002, 40:518-25.
- Amiri B, Ibrahim L, Butt TM. Antifeed ant properties of destruxins and their use with the entomogenous fungus Metarhizium anisopliae for improved control of crucifer pests. Biocontrol Science and Technology 1999;9:487-98.
- Frazzon AP, da Silva Vaz Junior I, Masuda A, Schrank A, Vainstein MH. In vitro assessment of Metarhizium anisopliae isolates to control the cattle tick Boophilus microplus. Vet Parasitol 2000;94(1-2):117-25.
- Shah PA, Pell JK. Entomopathogenic fungi as biological control agents. Appl Microbiol Biotechnol 2003;61(5-6):413-23.
- Scholte E-J, Ng'habi K, Kihonda J, Takken W, Paaijmans K, Abdulla S, et al. An entomopathogenic fungus for control of adult African malaria mosquitoes. Science (New York, NY) 2005;308(5728):1641-2.
- Zimmermann G, Z. The ‘‘Galleria bait method’’ for detection of entomopathogenic fungi in soil. Entomol 1986;102:213-5.
- Kodaira Y. Toxic substances to insects, produced by Aspergillus ochraceus and Oospora destructor. Agric Biol Chem 1961;25:261-2.
- Kaijiang L, Robert DW. The production of destruxin by the entomopathogenic fungus,Metarhixium anisopliae var. major jinvertpathol 1986;47:120-22.
- Demain AL. Pharmaceutically active secondary metabolites of microorganisms. Appl Microbiol Biotechnol 1999;52(4):455-63.
- Jegorov A, Sedmera P, Matha V. Biosynthesis of destruxins. Phytochemistry 1995;33:1403-5.
- Schwab EK, Keller NP. Regulation of secondary metabolite production in filamentous ascomycetes Mycol. Res 2008;112:225-30.
- Moon Y, Krasnoff SB, Vandenberg JD, Gibson DM, Churchill ACL. S., Genetic analyses of a peptide synthetase gene from the insect pathogen Metarhizium anisopliae. Fungal Genet Newsl 52Suppl517 2005.
- Aldridge DC, Turner WB. Structures of cytochalasin C and cytochalasin D from Metarhizium anisopliae. J Chem Soc C 1969;6:923-8.
- Roberts DW, Hajek AE, New H. Entomopathogenic fungi as bioinsecticides1992. 144-59.
- Espada A, Dreyfuss MM. Effect of the cyclopeptolide on the production of destruxins and helvolic acid by Metarhizium anisopliae. J Ind Microbiol Biotechnol 719 1997;19:90-215.
- Kuboki H, Tsuchida T, Wakazono K, Isshiki K, Kumagai H, Yoshioka T. Mer-f3, 12-hydroxy-ovalicin, produced by Metarrhizium sp. f3. The Journal of antibiotics 1999;52(6):590-3.
- Krasnoff SB, Sommers CH, Moon Y-S, Donzelli BGG, Vandenberg JD, Churchill ACL, et al. Production of mutagenic metabolites by Metarhizium anisopliae. J Agric Food Chem 2006;54(19):7083-8.
- Roberts DW, Leger RJ, In AI, Laskin JW, United L. St. Metarhizium spp2004. 1-70.
- Krasnoff SB, Keresztes I, Gillilan RE, Szebenyi DME, Donzelli BGG, Churchill ACL, et al. Serinocyclins A and B, cyclic heptapeptides from Metarhizium anisopliae. J Nat Prod 2007;70(12):1919-24.
- Dumas C, Robert P, Pais M, Quiot JM. vey, A. Insecticidal and cytotoxic effect of natural and hemisynthetic destruxin. CompBiochemPhysiol 1995;108:195-203.
- Parine NR, Pathan B, Nishanth VS, Bobbarala V, K. A. Antibacterial efficacy of secondary metabolites from entomopathogenic fungi Beauveria bassiana. Int J of Chemical and Analytical Sci 2010;1(5):94-6.
- Amiri-Besheli B, Khambay B, Cameron SML, Deadman ML, Butt TM. Inter-and intra-specific variation in destruxin production by insect pathogenic Metarhizium spp. and its signicance to pathogenesis Mycol Res 2000;104:447-52.
- Rhoden SA, Bongiorno VA, Azevedo JL, Pamphile JA, Garcia A, J. Antimicrobial Activity of Crude Extracts of Endophytic Fungi Isolated from Medicinal Plant Trichilia elegansA. Juss Pharm Sci b 2012;02(08):57-9.
- Castlebury LA, Sutherland JB, Tanner LA, HendersonCerniglia A, World J. L.C.E. Use of a bioassay to evaluate the toxicity of beauvericin to bacteria. Microbiol Biotechnol 119e121 1999;15.